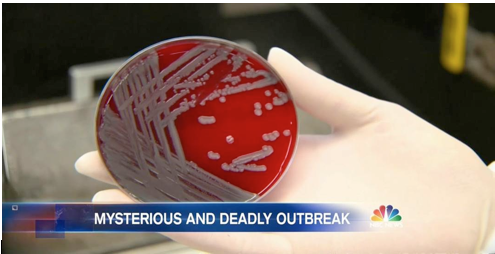

Phrasal verbs with
break and stand
Ingrid Vooglaid
2017
A phrasal verb is made up of a verb and an adverbial or a prepositional particle. It is used idiomatically to convey a special meaning completely different from the meaning expressed by the verb or the particle. The same verb followed by different particles conveys different meanings. Phrasal verbs consist of two or three parts – an ordinary verb and another word or words like in, for or off.



Break down

Break down

Break into

Break in
They smelled like what they were,
Wild Animals.
I took the first one that broke and forefooted the colt,
It hit the ground with a tremendous thump.
The horse struggled up and turned and shot out one hind foot,
Only to fall again and repeat the cycle three times over again.
I placed the blanket on the animal's back and stood stroking the animal;
The horse never moved.
I could see the soul of the horse.
My old daddy always said, "The purpose of breakin' a horse is to ride it"
So I grinned and booted the horse forward into a trot as we set out up the road.
https://sites.google.com/a/glenbrook225.org/chasing-horses/found-poem

Break in

Break up

Break up

Break off

Break out
Outbreak

Break through

Breakthrough

Break upon -
to discover itself suddenly to; to dawn upon.
To break with.
(a) To fall out; to sever one's relations with; to part friendship. "It can not be the Volsces dare break with us." --Shak. "If she did not intend to marry Clive, she should have broken with him altogether." --Thackeray.
(b) To come to an explanation; to enter into conference; to speak. [Obs.] "I will break with her and with her father." --Shak.
[1913 Webster]
To break away, to disengage one's self abruptly; to come or go away against resistance.
[1913 Webster]
Fear me not, man; I will not break away. --Shak. [1913 Webster]
To break loose.
(a) To extricate one's self forcibly. "Who would not, finding way, break loose from hell?" --Milton.
(b) To cast off restraint, as of morals or propriety.
To break forth, to issue; to come out suddenly, as sound, light, etc. "Then shall thy light break forth as the morning." --Isa. lviii. 8; [1913 Webster]
Note: often with into in expressing or giving vent to one's feelings. "Break forth into singing, ye mountains." --Isa. xliv. 23.
[1913 Webster]


Stand out

Stand up to vs for


Stand for
Stand up
- She stood up for him
- She stood up to him
- She stood up against his being elected
- She stood him up
Stand by and behind
- She was told to stand by
- She was expected to stand by their idea
- She stood behind him
- She stood behind their idea

Stand by
Meaning: Be ready and waiting for something to happen
Example: The emergency services were STANDING BY waiting for the plane to land.



Stand behind you

Stand behind an idea

Stand in for
STAND DOWN
Meaning: Leave a job or position so that someone else can take it
Example: The minister announced her intention to STAND DOWN at the next election.
STAND ABOUT, STAND AROUND
Meaning: stand doing nothing with no purpose.
Example: A. Don't just stand about with your hands in your pockets... give me a hand!
B. There were some young kids standing around outside the convenience store.
STAND BACK
Meaning: A. move a short distance away
B. think about a situation as if it doesn't involve you
Example: A. We had to stand back a little from the fire as it was getting too hot.
B. Stand back a second and think about what you're doing. Do you really want to do this?
STAND ASIDE
Meaning: A. move to one side to let sb/sth pass
B. stop doing a job and let someone younger take over
Example: A. Please stand aside, we're coming through.
B. It's time he stood aside and let his son run the business.
STAND OVER SB
Meaning: to watch someone while they are doing something, usually in order to make sure that they are doing it correctly.
Example: I’m fed up with him standing over me while I work.
Phrasal verbs with break and stand
By ingridv
Phrasal verbs with break and stand
- 1,514